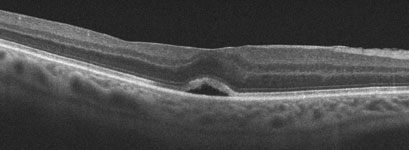

The retina is the light-sensing tissue at the back of the eye. A macular hole is a small, round defect in the center of the retina. Macular holes are most common in women in their early 60’s and are not associated with any systemic medical problems. Approximately 10% of patients with a macular hole in one eye will eventually develop a macular hole in the other eye.
With treatment, we are often able to close most macular holes with some improvement of central vision. The amount of visual improvement typically depends on the size of the hole and the length of time it has been present. The most important step in saving your vision is early detection and treatment. At Bennett & Bloom Eye Centers, we stay at the cutting edge of research and offer you our expertise and advanced diagnostic and treatment techniques to help maintain your vision.
A macular hole consists of a small, round defect in the central macula, the part of the retina we use for our straight-ahead vision. The hole is thought to be caused by the vitreous pulling on the central macula, creating a central defect in the retinal tissue. It usually occurs for no obvious reason (idiopathic), although a macular hole can also be caused by trauma or retinal detachment. Macular holes are most common in women in their early 60’s and are not associated with any systemic medical problems. Approximately 10% of patients with a macular hole in one eye will eventually develop a macular hole in the other eye.


A macular hole causes the central vision to become blurred or distorted. Patients may be completely asymptomatic, especially when the other eye sees normally. Some may experience progressive vision loss, although the vision will stabilize for most patients within 3 to 6 months of the macular hole developing.


You can’t diagnose a macular hole by looking in the mirror since your eye will usually look and feel normal. The diagnosis is made with a thorough retinal examination through a dilated pupil. Early stages of macular hole formation are often difficult to diagnose, often requiring additional testing such as OCT scanning which offers a near microscopic macular image.
Treatment for many patients with a macular hole is often not necessary since many remain asymptomatic. Surgery should be considered, however, for those people with a relatively new macular hole whose distortion, vision loss, or difficulty with depth perception make their daily activities such as reading and driving difficult.
A painless in-office injection of a gas bubble into the vitreous, similar to pneumatic retinopexy for retinal detachment, can successfully close a macular hole in about two-thirds of patients.
Vitrectomy surgery is performed in the operating room under local anesthesia. This advanced microsurgical technique allows us to restore vision by peeling and removing the vitreous from the macular surface and then filling the eye with a special gas bubble. The gas bubble helps to seal and flatten the hole postoperatively.

Patients go home immediately following surgery. There is usually minimal to no pain, except for minor irritation from sutures which absorb within several weeks of surgery. Patients need to look down to the floor for 1 week, which properly positions the gas bubble against the macular hole. Special equipment is available to help patients comfortably maintain this positioning (Comfort Solutions, Kelly Comfort Solutions, Vitrectomy Solutions) or watch TV while looking down (Make It Rite Mirror). Airplane flying and driving to higher altitudes is strictly prohibited while the bubble is present since it can expand causing severe pain and possible blindness. Even if the eye will ultimately see well, vision will be quite poor for a few months since the eye is not designed to see well through the bubble. The gas bubble absorbs on its own over several weeks to months, at which point it is possible to tell whether or not the hole has flattened. Vitrectomy successfully flattens the macular hole in over 90% of cases. With successful surgery, vision usually improves by about 50% although it may take several years for maximal vision to return.
The major side-effect of surgery is a cataract, with many patients requiring cataract surgery within a year or two of vitrectomy. Some patients may also notice side vision loss. There is about a 1 in 20 chance of a recurrent macular hole, along with a very small chance of secondary retinal detachment or infection.